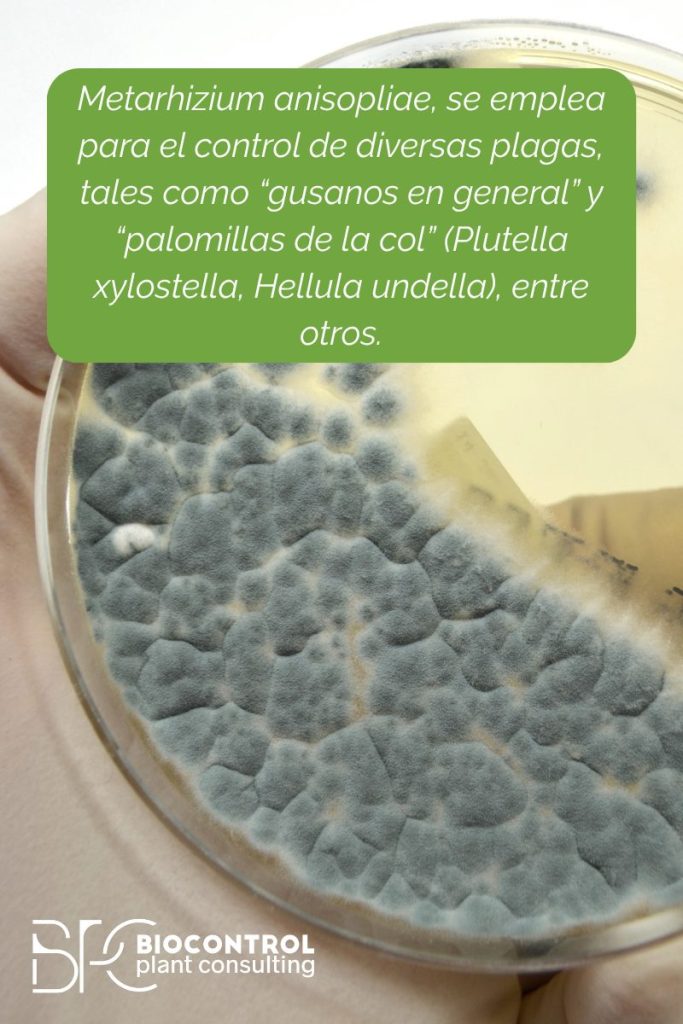
metarhizium anisopliae
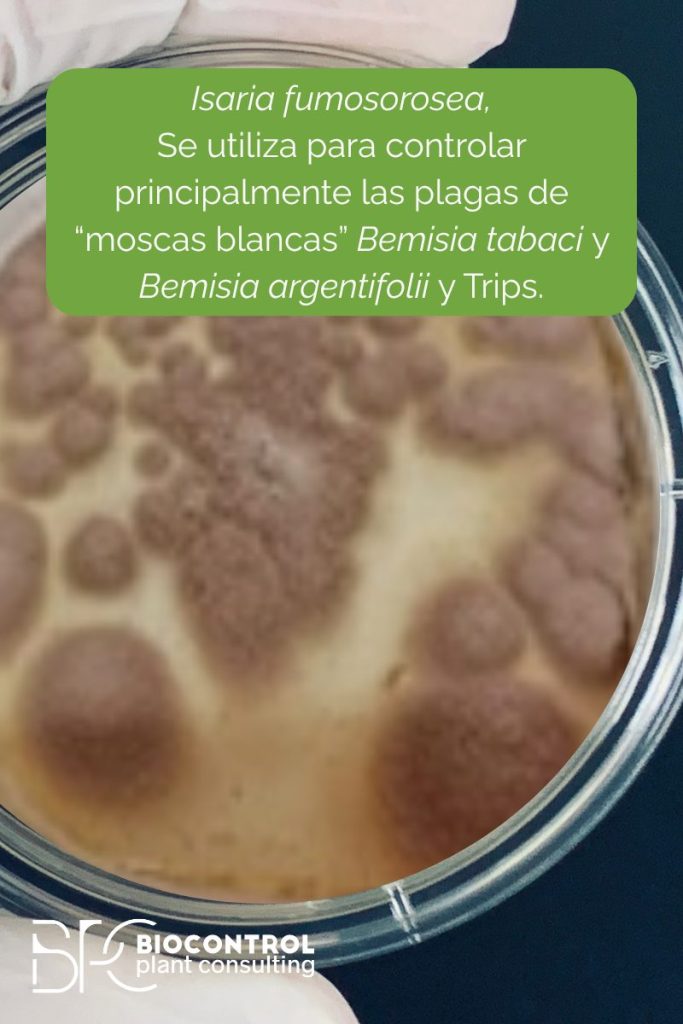
isaria fumosorosea

En la búsqueda de soluciones sostenibles para proteger nuestros cultivos, la naturaleza nos ofrece aliados poderosos y, a menudo, invisibles a simple vista. Uno de los recursos más prometedores del biocontrol moderno son los hongos entomopatógenos: microorganismos capaces de infectar y eliminar insectos plaga de forma natural, sin alterar el equilibrio ecológico ni depender de productos químicos sintéticos.
A diferencia de los pesticidas convencionales, que pueden causar resistencia o afectar especies beneficiosas, estos hongos actúan de manera precisa y eficiente, reduciendo el impacto ambiental. Pero, ¿qué son exactamente? ¿Cómo se aplican en agricultura? ¿Y cuáles son sus beneficios reales?
Acompáñanos a descubrir cómo los hongos entomopatógenos están revolucionando el manejo integrado de plagas.
¿Qué son los hongos entomopatógenos?
Los hongos entomopatógenos son organismos que infectan y matan insectos a través de un proceso biológico específico. A diferencia de bacterias o virus, los hongos no necesitan ser ingeridos para causar infección. Basta con que sus esporas entren en contacto con el exoesqueleto del insecto para iniciar el proceso de colonización.
Estos hongos penetran el tegumento del insecto, se desarrollan en su interior y liberan toxinas que lo debilitan hasta causarle la muerte. Posteriormente, el hongo emerge y libera nuevas esporas al ambiente, cerrando así su ciclo vital.
Los más conocidos:
- Beauveria bassiana
- Metarhizium anisopliae
- Isaria fumosorosea
- Lecanicillium lecanii

Un mecanismo de acción tan natural como eficaz
El proceso de infección suele seguir estos pasos:
- Adhesión: las esporas del hongo se adhieren a la cutícula del insecto.
- Penetración: mediante enzimas como quitinasas y proteasas, el hongo atraviesa el exoesqueleto.
- Colonización interna: el micelio se expande por los tejidos del insecto, provocando su debilitamiento.
- Producción de toxinas: se generan compuestos tóxicos que aceleran la muerte.
- Emergencia de nuevas esporas: el hongo emerge y se dispersa para infectar nuevos individuos.
Este ciclo puede completarse en pocos días, y lo más relevante es que actúa de forma específica, sin afectar a otros organismos no diana como abejas, sírfidos o aves.
Ventajas frente a otros métodos de control
- Baja toxicidad para humanos y fauna benéfica
- Persistencia en el ambiente: algunas formulaciones permanecen activas en el suelo durante semanas.
- Reducción del uso de pesticidas
- Compatible con el manejo integrado de plagas (MIP)
- No genera resistencia cruzada
- Apto para agricultura ecológica y regenerativa
Además, estos hongos se pueden combinar con bioestimulantes o feromonas para un enfoque más holístico
Casos de aplicación en la agricultura
Control de mosca blanca en tomate (Trialeurodes vaporariorum)
Beauveria bassiana ha demostrado ser especialmente eficaz para reducir las poblaciones de mosca blanca en cultivos protegidos, disminuyendo las aplicaciones químicas sin comprometer la producción.
Combate al gusano cogollero (Spodoptera frugiperda) en maíz
Metarhizium anisopliae se ha usado en parcelas de maíz con alta presión de plaga, logrando reducir el daño foliar y proteger el rendimiento.
Uso en cultivos orgánicos de lechuga
El uso de hongos entomopatógenos se ha convertido en una herramienta clave para horticultores que buscan certificaciones ecológicas, especialmente contra pulgones y trips.
Factores que influyen en la eficacia
Aunque su potencial es enorme, el éxito de los hongos entomopatógenos depende de múltiples variables:
- Humedad relativa: su germinación es más efectiva en ambientes húmedos.
- Temperatura: cada cepa tiene un rango óptimo de acción.
- Formulación y almacenamiento: las esporas deben mantenerse viables.
- Método de aplicación: foliar, al suelo o mediante sistemas de riego.
Por eso, la asesoría técnica especializada y la elección de productos certificados son fundamentales para lograr resultados consistentes.
Los hongos entomopatógenos son una demostración viva de cómo la naturaleza, bien entendida, puede ser nuestra mejor aliada en el campo. Incorporarlos al sistema de producción no solo mejora la sanidad vegetal, sino que también impulsa una agricultura más consciente, regenerativa y resiliente frente a los desafíos actuales.
¡Comparte este artículo con alguien que busque alternativas sostenibles!
Si quieres una asesoría personalizada, escríbenos directamente desde Contacto

